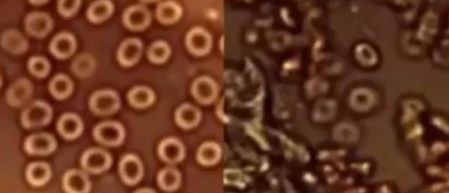

COMBIEN DE TEMPS RESTE-IL À VIVRE AUX VACCINÉS ?
Souvenons-nous du 20e anniversaire du 11 septembre en examinant l’un des sujets d’aujourd’hui moins publiés, mais dont on parle beaucoup. (Si vous voyez cet article, assurez-vous de le partager car il est probablement supprimé.)
Par Steven Fishman
J’ai confié cette question à un de mes amis, le Dr Mylo Canderian, Ph.D. [né Milos Iskanderianos, Corfou, Grèce, 1938], qui a développé le brevet pour l’oxyde de graphène à utiliser comme arme biologique hématologique en 2015.
En toute transparence, le Dr Canderian est ce que j’appellerais un «mondialiste génocidaire» qui suit le précepte dix des Georgia Guidestones, qui est très rarement discuté et qui déclare : «Ne soyez pas un cancer sur la Terre ; faites place à la nature.»
Le Dr Canderian est un contributeur médical à l’Organisation mondiale de la santé et soutient également Klaus Schwab et la «Grande réinitialisation», inaugurant une monnaie numérique mondiale qui est un objectif secondaire de l’OMS pour 2022. Il est d’avis que 95 % de la population mondiale consiste de «bouches inutiles à nourrir» qui doivent être euthanasiés le plus rapidement possible. «Regardez le centre-ville de Chicago, Baltimore ou Los Angeles», a-t-il déclaré, «et vous verrez clairement pourquoi les bouches inutiles doivent être abattues comme des chiens enragés.»
Le Dr Canderian a exprimé son mépris pour les «éducateurs infectieux» qui promeuvent la théorie critique de la race, et est convaincu que le «vaccin» mettra fin au «cancer humain sur la Terre». C’est un ardent partisan du devoir et de l’obligation de la franc-maçonnerie de débarrasser le monde de la «peste humaine». Pourtant, sur le plan personnel, lui et moi partageons une passion pour le même plat exotique servi à L’émince de Veau à Genève : Velouté de Colibri suivi de Langue d’Elan. Nous sommes tous les deux fans du chef Gaston Séré de Rivières, qui est un génie culinaire.
Alors, j’ai demandé à Mylo : «Comment les “vaccinés” peuvent-ils savoir avec certitude combien de temps ils leur reste à vivre une fois qu’ils ont été piqués ?» Il m’a présenté les informations, appelées «Formule de fin de cycle» en expliquant à quel point il est facile de faire ce calcul. «Le pouvoir de la simplicité», a-t-il dit. «Il y a un cycle maximum de dix ans entre l’injection et la fin du cycle» [ou la mort], a-t-il précisé. «Et c’est extrêmement facile à déterminer.»
Il a dit que n’importe quel hématologue peut le voir en quelques secondes sous un microscope, et encore plus facilement sous un microscope électronique. «Le pourcentage de sang affecté [ou contaminé] par ou avec l’oxyde de graphène est la réciprocité du calcul de fin de cycle», a-t-il divulgué.
En d’autres termes, un «inoculé» [comme il appelle toute personne piquée avec l’arme biologique d’injection létale d’autorisation d’utilisation expérimentale Eugenics] ayant une détérioration de 20% d’oxyde de graphène dans son sang vivra, à moins de tout autre critère d’entrée, pendant 8 ans. [10 ans moins 20%]. Quelqu’un avec 70% de détérioration de l’oxyde de graphène ne vivra pas plus de 3 ans. [10 ans moins 70%].
Le Dr Jane Ruby a récemment été interviewée par Stew Peters sur son podcast et a montré des exemples de ce à quoi ressemble le sang détérioré lorsqu’il est exposé à l’oxyde de graphène. L’oxyde de graphène, pour ceux qui ne le savent pas, est le composant des protéines de pointe de l’ARN messager et des prions, qui est en guerre avec le cœur, les poumons, le cerveau et le sang pour l’oxygène.
L’oxyde de graphène est une éponge à oxygène qui prive le corps de l’oxygène nécessaire et provoque de nombreuses complications, y compris, mais sans s’y limiter, un choc anaphylactique, une coagulation sanguine toxique, une paralysie pulmonaire mortelle, un cancer mitochondrial et un cancer endothélial.
Le point de vue du Dr Mylo Canderian est à peu près le même que celui de Klaus Schwab, Bill Gates et du PDG de Big Pharma : LAISSEZ-LES TOUS MOURIR !
J’ai demandé à Mylo quel était l’effet des deuxième et troisième injections et des boosters, et comment cela changeait le tableau de fin de cycle. Mylo a répondu: «Tout est mesurable grâce à des tests hématologiques. Plus les imbéciles reçoivent de piqûres et de boosters, plus leur sang sera mauvais au microscope, et plus vite ils se transformeront en engrais.
Enfin, je lui ai demandé comment le complot visant à tuer tant de milliards de personnes pouvait être gardé si secret par un tel groupe d’élites. Sa réponse fut : «Tu ne connais pas grand-chose à la franc-maçonnerie, n’est-ce pas, Steve ?»
Et voila.
Traduit de l’anglais par BibiCabaya (19 février 2021)
Source : Freedom From Government http://freedomfromgovernment.org/page/2/ , publié le 11 septembre 2021.
*
*
*
*
